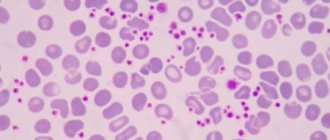
Тромбоцитопатия

Доброго времени суток, дорогие читатели. Сегодня мы поговорим про один из важнейших органов нашего тела и заботу о нем. Итак, речь пойдет о сердце и его питании. Выбирая полезные продукты для сердца, необходимо учитывать, что сердце — не просто мышца. На самом деле, это супер мышца.
Потому что состоит из сокращающихся волокон особого типа, способных работать постоянно, без отдыха, в течение многих лет. Эта способность отличает сердце от всех остальных мышц, которым после напряжения требуется отдых.
Самое главное в чем нуждается наше сердце
Чтобы сердце билось без отдыха всю жизнь, сердечной мышце-миокарду необходим постоянный приток крови. Кровь поступает в сердечную мышцу по коронарным артериям, первым ответвлениям главнейшего кровеносного сосуда организма — аорты. Если приток крови по коронарным артериям снижается или прерывается, сердце «жалуется» острой, давящей болью — основными симптомами сердечного приступа.
Забота о сердце требует прежде всего поддержания коронарных артерий в чистоте, чтобы кровь беспрепятственно поступала по ним к миокарду, позволяя ему выполнять свою работу.
Исходя из этого, ведущие кардиологи разработали самые лучшие рекомендации. Эти пять простых правил, сегодня могут спасти множество сердец.
Жиры, какие полезны?
Правило первое и основное: продукты для сердца должны содержать меньше жиров и при этом лучшего качества.
В нашем рационе должно содержаться некоторое количество жиров – не больше 30% от общего числа потребляемых калорий. Так, для рациона в 2000 калорий это составляет 67г жира (чуть больше четырёх столовых ложек растительного масла).
Обычный рацион современного человека богат жирами: жиры в нём составляют от 45% до 60% от общего числа потребляемых калорий. И в первую очередь, это насыщенные жиры, содержащиеся в мясе, молоке и маргарине. Таким жирам сопутствует холестерин, и сами они стимулируют выработку холестерина в организме.
Однако избыток жира и холестерина откладывается на стенках коронарных сосудов, питающих сердечную мышцу. В результате, это снижает подачу крови в сердце и ослабляет его. Когда жир и холестерин перекрывают коронарную артерию, это приводит к инфаркту миокарда.
Для здорового сердца в питании необходимо:
- Снизить общее количество потребляемых жиров.
- Снизить или исключить трансжиры, присутствующие в гидрогенизированных растительных маслах, некоторых видах маргарина и жареной пище.
- Заменить насыщенные (вредные) жиры (содержащиеся в основном в мясе, колбасных изделиях, цельном молоке, масле и сыре) ненасыщенными (полезными) растительными жирами. О холестериновой диете читайте тут.
Как продукты для сердца, используйте ненасыщенные растительные масла, такие как оливковое, подсолнечное, кунжутное и другие.
Хорошей альтернативой также будут изделия из цельнозерновой муки.
Ну а бобовыми и орехами нужно заменить такие продукты, как маргарин, колбасы, сыр.
Заведите пушистого друга
Заведение собаки в дом может на самом деле принести пользу вашему здоровью сердца. В частности, для перенесших инфаркт и инсульт людей, владение собаками, было связано вскоре с лучшим здоровьем сердца и более длительной жизнью, согласно опубликованному в октябре 2020 года метаанализу Circulation: Cardiovascular Quality and Outcomes .
Владельцы собак с большей вероятностью будут заниматься необходимыми для сердца мероприятиями, включая повышенную физическую нагрузку и более здоровое питание. Владение собакой обычно приводит к более частой ходьбе или бегу, что может создать эффект домино с другими вариантами здорового образа жизни.
Кардиологи рекомендуют
Например, грецкий орех считается превосходной пищей для людей страдающих от недугов коронарных сосудов. Его можно включить в полезные продукты для сердца по трём причинам:
- Он богаты жирными кислотами – главным поставщиком энергии клеткам мышцы сердца. В случае с остальными клетками, в том числе с нейронами, в качестве основного топлива выступает глюкоза.
- В нем имеется витамин В1, влияющий на правильную работу мышц, в том числе – на мышцу сердца.
- Орехи содержат внушительное количество фосфора и калия (502мг на 100г сырого продукта) и одновременно, они бедны натрием, что способствует здоровью сердца и сосудов.
- Еще в них обнаружено также приличное количество железа, кальция и магния.
- Наконец, они препятствуют наслоению холестериновых бляшек на внутреннем выстилающем слое артерий, снижая уровень холестерина в крови. Как известно, чем меньше холестерина в крови, тем ниже риск артериосклероза (сужение артерий) и тем лучше циркуляция крови.
Таким образом, грецкие орехи обязательно должны быть включены на регулярной основе в рацион тех, кто страдает от сердечной недостаточности, стенокардии или предрасположен к сердечному приступу.
Кроме того, употребление грецких орехов рекомендуется и тем, кто перенёс инфаркт миокарда и проходит реабилитацию.
Например, в проведённом в Калифорнии исследовании изучались привычки 25 000 человек. Среди тех, кто ел грецкие орехи пять и более раз в неделю, риск сердечного приступа был минимальным. Кстати, их много есть и не нужно, допускается до 10 орехов в день.
Пейте умеренно
Ученые все еще не определилось с тем, как алкоголь влияет на наши сердца. Некоторые исследования показывают, что алкоголь может вызвать небольшое повышение уровня «хорошего» холестерина.
Однако, аргумент заключается в том, что вы можете получить те же самые преимущества от физических упражнений и употребления фруктов и овощей без потенциальных негативных побочных эффектов, которые есть от употребления алкоголя.
В настоящее время, рекомендуется мужчинам ограничиваться одним-двумя бокалами слабоалкогольных напитков в день, а женщинам — не более одного бокала в день.
Продукт для обновления сердечно-сосудистой системы.
Если говорить про полезные продукты для сердца то стоит еще упомянуть о таком продукте долгожителей как соя. Соевые бобы — уникальны среди всех бобовых. Так в них по оценкам специалистов содержится 16,6% жиров, а в остальных бобовых — 1%. Чувствуете разницу? И это растительные ненасыщенные жиры, которые как раз-таки поставляют энергию для сокращения сердечной мышцы.
Однако соя помогает снизить уровень холестерина в крови еще по трем причинам: в ней есть клетчатка, изофлавоны и фитостерины. В результате последних исследований было доказано, что эти четыре мощных фактора сои способны даже обращать вспять сердечно- сосудистые заболевания. Так у пациентов употреблявших сою увеличивался просвет артерий и повышалась их эластичность.
То есть запускались процессы, оздоравливающие коронарные артерии, а значит и сердце.
Неудивительно, что врачи кардиологи с мировым именем включили сою в самые полезные продукты для здоровья и укрепления сердца. Подробнее в материале об экстраординарной пользе сои по ссылке.
Наиболее распространенные профилактические проверки здоровья сердца
69. Тест физической нагрузкой, или велоэргометрия, является наиболее часто применяемым методом обследования как для диагностики начальных стадий коронарной болезни сердца, так и для оценки степени тяжести болезни.
70. Допплер-эхокардиография – обследование сердца при помощи ультразвука, во время которого можно оценить состояние сердца, обнаружить патологии и т. д.
71. Мониторинг Холтера – этот метод помогает врачу оценить нарушения сердечного ритма в течение 24 часов, определить тип аритмии у пациента, частоту и длительность эпизодов нарушения ритма.
72. Мониторинг кровяного давления на протяжении 24 часов – метод, который применяют, чтобы обнаружить изменения кровяного давления в течение суток.
73. Электрокардиограмма – один из самых важных методов обследования, на котором видны колебания работы сердечной мышцы.
Вашему сердцу может быть несладко
Правило второе: употребляйте меньше сахара.
Как известно, избыток сахара в рационе превращается в жир и повышает уровень триглицеринов ( одного из типов жиров) в крови. Всё это способствует закупорке коронарных артерий, питающих сердечную мышцу.
Кроме того, белый или очищенный сахар, будь то сахароза ( обычный сахар), фруктоза или глюкоза, в отличие от природного сахара, находящегося в свежих фруктах, не содержит витаминов, минералов, клетчатки или антиоксидантов, необходимых сердцу.
Поэтому для здорового сердца рекомендуется снизить или исключить потребление сладостей, пирожных, конфет, изготовленных из белой муки и рафинированного сахара.К примеру, если хочется сладкого, используйте свежие или сушёные фрукты.
Физическая активность
Физические нагрузки для здорового человека должны быть умеренными, особенно если человек ранее не занимался спортом или физкультурой, и вдруг внезапно решил начать это делать. Сердце должно подвергаться посильной нагрузке. Вполне достаточно начать с небольшой зарядки по утрам. Затем дополнить легкими пробежками, плаванием в бассейне, игровыми видами спорта. В качестве базы упражнения рекомендуется выполнять следующие: приседания, махи руками и ногами, наклоны в сторону, отжимания, упражнения на пресс, растяжка.
В качестве оптимального примера начинающим активно заниматься спортом новичкам без сердечной патологии можно порекомендовать аэробные т.н.з. кардио-нагрузки в разумных количествах. С повышением времени тренировки исходя из выносливости, по пульсу и самочувствию. Лучше всего для этого подойдут эллиптические тренажеры, бег трусцой, на дорожке. Важно, что для эффективной тренировки нужно выбирать не экстремальные нагрузки, а более длительные, но «посильные». Пульс при этом должен находиться в «аэробной зоне» — лучше всего между [(190 уд/мин) минус (возраст, лет)] и [(150 уд/мин) минус (возраст, лет)]. Т.е. для 30-летнего человека эффективная и относительно безопасная зона для укрепления сердечной мышцы — от 120 до 160 ударов в минуту. (Лучше всего брать нижние-средние значения, т.е. 120 — 140 уд/мин, особенно при недостаточной тренированности).
Людям со здоровым сердцем, уже занимающимися профессионально или выполняющими регулярные занятия в фитнес-центрах или в спортзалах, программу нагрузок следует составлять индивидуально с помощью тренера, а увеличивать ее дозированно и постепенно.
Что касается активизации пациента с уже имеющимися сердечно-сосудистыми заболеваниями, то она должна проводиться только после консультации врача лечебной физкультуры.
Видео: примеры гимнастических упражнений для укрепления сердца
Видео: пример мнения/практического опыта о тренировке сердца спортсменов
Сладости для сердца
Лучший источник калия
Безусловно, говоря про продукты какие полезны для сердца, нельзя не упомянуть о бананах. На сегодня доказано, что бананы — идеальная пища для сердца. Так как, в них в большом количестве найдены такие минералы как: магний, калий и железо. Более того, банан, из-за повышенного содержания калия в купе с магнием и железом, признан едва ли не самым лучшим источником полезных для сердца минералов.
К примеру, в банане на 100г съедобной части имеется 396 мг калия. Большим содержанием калия могут похвалится только финики и авокадо. Банан признан лучшим по составу фруктом для больных стенокардией, аритмией, сердечной недостаточностью или пережил инфаркт.
Так же его рекомендуют как средство от повышенного давления и артериосклероза. Рацион, обогащенный калием, предотвращает аритмию, повышение давления (артериального), а значит и инсульт. Более того, установлено, что калийная диета является профилактикой некоторых видов рака.
Продукты богатые калием. Лидерами являются курага, изюм, петрушка, шпинат и авокадо. Затем следуют орехи, кабачки, чечевица, картофель, гречка и овсянка, после — банан, виноград, тыква и морковь.
Краткое, но полезное видео про продукты богатые калием.
Поставщик простых сахаров
Ещё один удивительный фрукт, который с успехом заменяет сладости – виноград. Виноград диетологи рекомендуют как еще один важный источник питания сердца, будь-то здорового или больного. Итак, он необходим как:
- Источник простых сахаров для стабильных сокращений сердца. Такие сахара еще один источник непосредственного питания сердечной мышцы помимо жирных кислот.
- Важный поставщик калия, а еще –магния и кальция. Одним словом, минералов так необходимых нашему сердцу для бесперебойной работы.
- Поставщик фенольных фитохимических веществ (ресвератрол и флавоноиды), оказывающих положительное влияние на кровоток особенно, по коронарным артериям питающим сердце. В результате, снижается способность тромбоцитов формировать тромбы и уменьшается засорение артерий.
В результате экспериментов были выявлены положительные свойства винограда и виноградного сока. Которые проявились в улучшении кровотока, расширении артерий, уменьшении накопления холестериновых бляшек, и снижении тромбообразования. Можно ли ожидать лучшего от продукта, сохраняющему здоровыми нашу сосудистую систему и сердце?
Было установлено, что если, начиная с лета и оканчивая глубокой осенью систематически употребляют виноград, а в зимнее и весеннее время кушать изюм, то в ответ на такие простые усилия значительно улучшится состояние вашего сердца. Об этом свидетельствуют отзывы многих пациентов с сердечными недугами. Не зря кардиологи во время восстановления после инфаркта, настоятельно рекомендуют включить в рацион виноград. Эта мера позволяет подавить развитие коронарного артериосклероза. Таким образом, виноград также следует включить в полезные продукты для нашего сердца.
Препараты для укрепления и поддержания сердечной мышцы
Укрепить сердечную мышцу можно и посредством фармацевтических средств. Это крайняя мера, но чаще всего без нее обойтись не удается.
Какие наименования и группы можно порекомендовать:
- Препараты для защиты тканей миокарда. Так называемые кардиопротекторы. Милдронат, Рибоксин и прочие из данной группы. Чтобы поддержать сердце пожилому и молодому человеку, имеет смысл принимать кардипротекторы длительное время, потому как напрямую влияют на обменные процессы в тканях миокарда, снижают потребность в кислороде, восстанавливают трофику (питание).
- Витаминно-минеральные комплексы c калием и магнием. Магне B6, Аспаркам или Панангин и многие другие как позволяют подпитать сердце и улучшить его работу. Самовольно пить не рекомендуется, потому как велика вероятность побочных эффектов. Лучшим решением станет консультация специалиста.
Прочие медикаменты используются только при диагностированных и подтвержденных заболеваниях, например хронической сердечной недостаточности. Потому их нет смысла назначать без показаний. Это может быть смертельно опасно.
О каких препаратах идет речь?
- Гликозиды. Восстанавливают и усиливают сократительную способность сердца, их используют с большой осторожностью, потому как подобные средства имеют массу побочных явлений, тяжело переносятся пациентами при продолжительном применении.
- Мочегонные. Диуретики для снижения нагрузки на кардиальные структуры. Лекарства позволяют вывести избыток жидкости и восстановить нормальный объем циркулирующей крови.
- Противогипертонические. Ингибиторы АПФ, средства центрального действия, блокаторы кальциевых каналов и прочие. По необходимости, при развитии избыточного давления, которое не корректируется естественными методами. Дозировки также подбирает врач, постоянно «подгоняет» их при необходимости.
- Антиагреганты. Для нормализации текучести крови. Требуются не всегда. Обычно это наименования на основе Аспирина, подходящие для длительного использования (например, Тромбо-асс и другие).
Препараты для укрепления сердечной мышцы это кардипротекторы вроде Милдроната или же медикаменты, в основе эффекта которых лежит нормализация ионного обмена: Аспаркам и иные.
Прочие не применяются без показаний, потому как это крайне опасно и может привести к непредсказуемым последствиям.
Защитники артерий
Правило третье: увеличьте потребление антиоксидантов
Антиоксиданты защищают стенки артерий от отложений от холестерина и насыщенных жиров. Если артерии здоровы и чисты, сердце работает намного лучше. Хорошие источники защитных антиоксидантов – фрукты.
Витамин Е – это антиоксидант, борющийся с жирами. Он предотвращает окисление плохого холестерина – ЛПНП, который является первым шагом в формировании жировых отложений в артериях. Лучшие природные источники витамина Е: семена подсолнечника, миндаль, пророщенная пшеница, нерафинированное оливковое масло.
Витамин С сохраняет эластичность артерий, прежде всего коронарных. Это мощный антиоксидант, участвующий в усвоении витамина Е. Лучшие природные источники: смородина, киви, цитрусовые. В мясе, молоке, рыбе и яйцах витамин С не содержится.
Ликопин- это ярко-красный овощной пигмент-антиоксидант. Исследование, проведённое Гарвардским университетом среди 28 345 женщин, показало, что повышеннный уровень ликопина в крови приводит к двукратному снижению риска сердечно-сосудистых заболеваний. Лучшие природные источники ликопина – помидоры, арбузы, папайя.
Магний. Чем лучше организм обеспечивается магнием, тем меньше риск возникновения сосудистых заболеваний и инфаркта миокарда.
Продукты, богатые магнием: семена тыквы и кунжута, миндаль, бобовые, в том числе соя и цельнозерновые продукты. Напротив, мясо и молоко как раз-таки бедны магнием.
Продукты богатые магнием на видео:
Укрепление ослабленного сердца при усложненных сердечных недугах: советы кардиолога
Особенно важно придерживаться советов кардиологов людям, которые перенесли или имеют легкие формы патологии.
К выше описанным рекомендациям нужно добавить следующие:
- Посещайте специалиста данного профиля.
- Периодически проходите обследование сердечно-сосудистой системы. Сдавайте необходимые анализы и проходите обследования (ЭКГ, УЗИ и ЭХО, анализы). Посещаемость врача зависит от вашего заболевания, но не менее одного раза в год. Кардиолог будет следить за динамикой изменений, и корректировать лечение.
- Проверьте другие органы, поскольку любая другая болезнь может нарушать работу сердца.
- Обязательно придерживайтесь предписаний врача. Самолечение может негативно отразиться на миокарде и только усугубит течение болезни.
Необратимые сердечные перемены очень сложно предотвратить, иногда уже даже невозможно.
При сложных формах болезни сердца (миокардит, кардиосклероз и др.), оно теряет способность перегонять кровь. Поэтому нужно не только скорректировать образ жизни, но и принимать кардиопротекторы и дополнительные препараты для лечения всего организма.
При тяжелой форме
Неподходящий продукт для сердца
Правило четвертое: ешьте меньше мяса.
Мясо, особенно красное (говядина, свинина и баранина), вредно для сердца по следующим причинам:
- Оно содержит насыщенные жиры и холестерин, закупоривающий сосуды.
- Гемовое железо в мясе лучше усваивается организмом, чем негемовое из растительной пищи. Однако, такое железо способно повреждать коронарные артерии. Так как имеет возможность обходить контроль системы распределения и обмена железа в организме. В результате с увеличением потребления мяса возрастает и риск возникновения инфарктов о чем свидетельствует статистика и современные медицинские исследования.
- Белки мяса распадаются с образованием кислых продуктов, способствующих развитию атеросклероза коронарных артерий.
- Мясо может быть загрязнено токсинами, тяжёлыми металлами, диоксинами, пестицидами и гормонами.
- Мясо не содержит никаких защитных антиоксидантов.
Клюква
Красные ягоды содержат большое количество антиоксидантов, а значит, защищают организм от вредных воздействий. Клюква помогает иммунитету, укрепляет сосуды, полезна для профилактики образования тромбов.
Клюква способствует очищению организма, нормализует уровень холестерина, укрепляет сосуды. Она способствует расширению венозных сосудов, что улучшает кровоток и снижает давление.
Чем защитить своё сердце? Инфографика Подробнее
Не насолите своему сердцу
Правило пятое: употребляйте меньше соли.
Как известно, при обильном потреблении соли содержащийся в ней натрий способствует развитию атеросклероза и повышает давление, что создаёт излишнюю нагрузку для сердца и сосудов.
Сегодня диетологи настоятельно рекомендуют снизить или исключить потребление готовых консервированных блюд и солений с высоким содержанием соли.
С этой целью, используйте в небольших количествах нерафинированную морскую соль (содержит магний и другие минералы, нейтрализующие негативное действие натрия).
Важный совет: количество соли можно снизить, приправляя блюда лимоном, чесноком и ароматическими травами.
Фрукты и сухофрукты
Не зря появилась поговорка: «Яблоко в день оставит доктора без работы». Эти чудесные фрукты обеспечивают питание для сердца. Продукты, содержащие минимум калорий и максимум пользы, при этом еще и очень вкусные – все это про румяные плоды. В них содержится клетчатка, а это самый необходимый элемент для снижения уровня холестерина. Входящий в состав калий помимо всего прочего активизирует выделительную систему, снижая отеки, а пектин выводит из организма вредные вещества. Но не только яблоки позволят вам противостоять заболеваниям сердца.
Гранат разжижает кровь, защищает от атеросклероза и уменьшает количество холестерина. Еще один полезный продукт – это грейпфрут. Он не только борется с преждевременным старением сердечной мышцы, но и обеспечивает организм витаминами. Нельзя забыть и про авокадо. Этот потрясающий плод содержит большое количество калия и полиненасыщенных жирных кислот. Именно такой состав позволяет организму бороться со стрессом и высоким давлением.